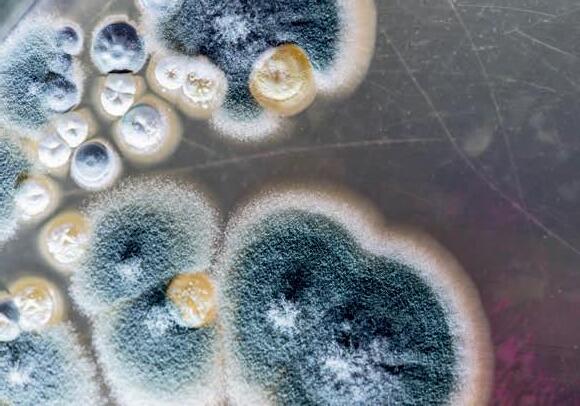

•
•
•
•
•
•
•










![]()





•
•
•
•
•
•
•










This section has been created to give you easier access when searching for a trusted real estate affiliate. Take a minute to familiarize yourself with the businesses sponsoring your magazine. These local businesses are proud to partner with you and make this magazine possible. Please support these businesses and thank them for supporting the REALTOR® community!
BUILDER
Perry Homes, LLC (972) 629-3900 perryhomes.com; brittonhomestexas.com
Shaddock Homes (972) 526-7700 ShaddockHomes.com
HOME INSPECTION
Greenworks Inspections and Engineering (832) 209-7199 greenworksinspections.com
Inspect360 (817) 754-0360 inspect360.com
MOLD SERVICES
Culley Enviro (817) 939-1643 culleyenviro.com
MORTGAGE LENDING
Cherry Creek Mortgage
- The Aldredge Team (817) 602-0348 TheJeffersonTeam.com
Guild Mortgage Adams
Mortgage Group (817) 393-3636 theadamsmortgagegroup.com
Major Money Matters
Major Singleton (808) 763-6831 majormoneymatters.com
Mortgage Matters (469) 807-1300 mortgagematters.us
Neighborhood Loans
Tanner Graham (817) 527-9670 people.rate.com/ tanner-graham-1916291
Still Waters Lending (214) 518-6513 stillwaterslending.com


MOVING COMPANY
Black Tie Moving
Tyler Coleman (512) 605-7328 blacktiemoving.com
PHOTOGRAPHY
DayDream Photography
Landon Day (817) 983-1204 daydream photography.net
RESIDENTIAL/ COMMERCIAL LENDER
Hometown Lending (972) 322-4472 hometownlend.com
ROOFING
Deluxe Roofing & Construction (817) 247-8628 deluxeroofingdfw.com

Hargrove Roofing
Greg Esquilino (214) 838-8778 hargroveroofing.com

PROCO Roofing
Megan Valentine (817) 975-1403 procoroof.com
Results Roofing
Quinton Hill (817) 808-3218 popl.co/card/KsiKVliN/1/preview
TITLE COMPANY
Independence Title
Sue Smith (682) 478-0005 independencetitle.com
Patten Title Company
- Ft. Worth (817) 435-2035 PattenTitle.com
Texas Secure Title (817) 519-8800 texassecuretitle.com
VIDEOGRAPHY/ PHOTOGRAPHY
studioUSA (469) 955-5833 studiousa.live



























“It’s Not the Market.
If there’s one thing I’ve learned over the past few years working with top real estate agents in DFW, it’s this: The best of the best don’t let the market define their success.
Yes, the market shifts. Interest rates rise and fall. Inventory tightens. Headlines scream uncertainty. But the top producers? They rise anyway. They choose grit over excuses. They double down on relationships, sharpen their skillset, and refuse to sit back and wait for things to “go back to normal.”
So this August, I want to challenge you: Stop watching the market and start watching your mindset.
I see it firsthand. Ashley, an RP Top Agent who also is on the Real Producers Team, is having one of her best years yet—not because everything is easy, but because she shows up every day with intention, focus, and drive. Her husband, Reece, said it best: “She’s making it happen.”
And that’s the mindset I see echoed across so many of you who grace these pages month after month.
We created Real Producers to connect and celebrate agents like you—people who don’t just survive in a tough market, but thrive. Because it’s not the economy. It’s not the season. It’s not the

interest rates. It’s you. And how you choose to respond.
We just wrapped up our August 7th Masterclass, where a panel of experts unpacked how to leverage AI in business. The agents who showed up? They didn’t do it because they had time to kill. They did it because they know the best investment they can make is in themselves. They’re showing up. They’re learning. They’re sharpening their edge.
The truth is, mindset is what separates those who get by from those who break through. And that’s exactly why we’re fired up for what’s coming next.
Mark your calendars: RP Elevate is happening September 29–30 at the Loews in Arlington.
This isn’t just another conference; it’s a chance to be in the room with agents and leaders from across the country—including powerhouse speakers like Rory Vaden, Molly Bloom, and Tom Ferry. The kind of people who stretch your thinking and raise your standard.
If you’re ready to be inspired, sharpened, and equipped to dominate this next season—don’t miss it.
Here’s to showing up, staying sharp, and keeping the right mindset, no matter what the market does.
Jordan Espeseth Founder/Owner, DFW Real Producers








$6,502,677,281 14,272 SALES VOLUME TOTAL TRANSACTIONS AVERAGE TRANSACTIONS PER AGENT
AVERAGE SALES VOLUME PER AGENT $13,005,355 28.5





In business, success is typically measured in numbers—sales closed, volume reached, awards earned. But for Brittany Fish, a Fort Worth-based real estate agent with RJ Williams & Co Real Estate, success looks like something else entirely. “It’s not about reaching a destination,” she says. “Success, for me, is growing in faith, serving others, and deepening my relationship with my family and my Creator, rather than chasing worldly accomplishments or possessions.”
It’s this heartfelt foundation—rooted in Jesus, family, and a fierce loyalty to the Texas Rangers—that has shaped every corner of Brittany’s life and career.
Raised in Irving, Texas, Brittany grew up surrounded by strong family values and a close-knit church community.
“Church was a big part of our lives,” she recalls, “and it’s actually where I met my husband. We’ve known each other since we were little kids.” That childhood friendship blossomed into a lifelong partnership—27 years of marriage, having three sons, and navigating the highs and lows of entrepreneurship together.
Before real estate, Brittany spent years shaping young lives in the public school system, specializing in deaf education. She taught in Irving ISD and later became an educational diagnostician for Northwest
ISD. “I earned my bachelor’s at TCU and my master’s at UNT,” she explains. But her trajectory shifted after the heartbreaking death of her second son shortly after birth. “I just could not return to traditional education after that. I needed a different path.”
Leaning on the entrepreneurial spirit she inherited from both her father and also her husband, Brittany purchased a Curves fitness franchise in 2002, later adding an LA Boxing franchise to her portfolio. But when the 2008 crash hit, it nearly wiped everything away. “We almost lost it all,” she says. “After that, I stepped back. I was scared to take risks. I became a stay-at-home mom for several years, which I would not change for anything. I love that I had that time with my boys to just be ‘Mom.’”
Then, in the summer of 2017, something changed. “My boys were growing up and I decided to get my real estate license,” she says. “And I’ve never looked back.” What started as a career pivot turned into a calling. Brittany’s love for people, her background in education, and her sharp sense for business made real estate a natural fit. “Helping people achieve their dreams through one of the biggest investments of their lives—it’s incredibly rewarding. This doesn’t feel like a job. It feels like a privilege.”

STUDYING THE BIBLE IS ONE OF THE BIGGEST JOYS IN MY LIFE.”
And it shows. Since 2018, she’s closed over 200 deals, been named a Top Producer at her brokerage every year (save for 2024, when she jokingly notes her broker’s wife “outperformed us all!”), and earned Real Producers’ Top 500 award from 2022 to today. But numbers don’t tell the whole story. Brittany’s favorite part of being an agent? “Meeting new people and guiding them through life’s transitions—whether they’re joyful, bittersweet, or challenging. I cherish those relationships.”
Of course, being a top-tier agent comes with its challenges. “This business doesn’t stop,” she admits. “People celebrate Fridays—but for me, Friday
means planning for a packed weekend of showings, open houses, and negotiations.” She laughs when describing how quickly her schedule can change. “One minute, I have nothing going on. The next, I’m showing 22 homes in two days!”
That constant hustle makes finding balance a daily challenge. “My biggest struggle is managing time because real estate does not stop. It is a 24/7 job. Another challenge is that I try not to let real estate transactions weigh too heavily on me, but God wired me to feel deeply. When things don’t go as planned, it’s difficult for me not to take it personally.”
Still, Brittany stays grounded in her faith. She’s a dedicated participant in Bible Study Fellowship, walking through Scripture alongside a global community. “Studying the Bible is one of the biggest joys in my life,” she shares. “It brings clarity and peace in the middle of chaos.”
Her family remains her cornerstone. She and her husband, David, both run successful businesses— his, a thriving HVAC company; hers, a growing real estate enterprise. Their sons are equally impressive: Landry, 24, is a rising star in real estate himself; Hudson, 21, is finishing his degree in petroleum engineering at UT Austin; and Logan, though he passed away as a baby, remains a cherished part of their family. “He would be 23 this year,” Brittany says softly. “He’s always in our hearts.”
When she’s not closing deals or studying Scripture, you’ll find Brittany cheering on the Texas Rangers. “We’re season ticket holders—going to the ballpark is one of my favorite things in the world,” she says. “Attending games with my family brings me so much joy.” Instead of traditional gifts, the Fish family would rather invest in experiences. “We’d rather take a trip or spend time together than unwrap something material. Making memories together is what matters most.”
As for advice to aspiring real estate agents, Brittany doesn’t mince words. “Treat others the way you want to be treated. Stay self-motivated. Treat every client like they’re your only one—whether it’s a $200,000 home or a $5 million estate. Write down your goals, know your market, and stay humble. Your work ethic will set you apart.”

Brittany Fish is more than a top-producing real estate agent. She’s a woman of faith, a fierce mother and wife, a devoted Rangers fan, and a shining example of how life’s detours often lead to divine purpose. “Some people call it luck,” she says. “But I believe luck is just preparation meeting opportunity. God has paved this path for me—I’m just walking it with open hands and a grateful heart.”




WRITTEN BY
KATHERINE H. FONDREN
PHOTOS BY
JOHN WALSH, PREMIER
PROPERTY MEDIA
In the high-stakes world of relocation, where stress can run high and expectations even higher, Tyler Coleman, branch manager of Black Tie Moving, stands out for his commitment to professionalism and service to his clients. For Tyler, moving isn’t just a job—it’s a deeply personal mission shaped by his own life experiences and a passion for exceptional customer care.
Tyler’s story begins in the heart of Texas. Born in the Dallas-Fort Worth area, he spent his childhood crisscrossing the state as his father, a high school football coach, moved from one town to the next.
“Growing up, we moved every two to three years,” Tyler recalls. “I know firsthand how stressful it can be, and that’s why I’m so passionate about making sure our clients’ moves run as smoothly as possible.”
This personal understanding of the upheaval that moving can bring led Tyler to Black Tie Moving, a company that he joined at the ground level.
Starting as a mover, Tyler quickly demonstrated a knack for leadership and customer service, climbing the ranks to become a driver, crew lead, and eventually transitioning into operations and branch management.
Black Tie Moving is not your average moving company. Under Tyler’s leadership, the DFW branch has become synonymous with world-class professionalism. “We take great pride in removing as much stress from our clients as possible during their transition,” Tyler says. This commitment to excellence isn’t just a slogan; it’s the foundation upon which the company operates.
One of the key differentiators for Black Tie Moving is its approach to staffing. “All of our employees are background checked and drug tested,” Tyler explains. “We also pay our employees more than 99% of moving companies to attract top talent. We like to know who we’re sending into our clients’ homes.” In an industry where many companies rely on contractors or day laborers, Tyler’s emphasis on hiring and retaining top-tier employees ensures that every client receives the highest level of service.
Tyler’s leadership style is as hands-on as it gets. He is involved in every aspect of the moving process, from the initial estimate to the final box being unpacked. “I will personally estimate and book their move, handpick the guys who perform the move, and even give the clients my

I know firsthand how stressful it can be, and that’s why I’m so passionate about making sure our clients’ moves run as smoothly as possible.
direct cell phone number so they can always reach me with any questions or concerns,” he says. This level of personal attention sets Black Tie Moving apart in a crowded market.
Tyler’s journey with Black Tie Moving has taken him far beyond DFW. After three years with the company, he was given the opportunity to open a new office in Nashville. It was there that he met his wife, and after another
successful stint in Austin, Tyler returned to DFW in the summer of 2022 to run the company’s largest branch. “If you would have told me 12 years ago I would be in the moving industry as a profession, I would’ve laughed at you,” Tyler admits. “But I found a rapidly growing company with room for growth in a great environment providing superior customer service.”
This attitude—paired with a relentless drive to succeed—has
been the cornerstone of Tyler’s career. “Every problem has a solution,” he says. “Some people will sulk or get wound up about a problem; I strive to find the solution.” It’s this can-do attitude that has propelled him to the top of his field and earned Black Tie Moving a stellar reputation in the industry.
Despite the demands of his role, Tyler places a high value on worklife balance. With two young sons,

three years old and seven months, and a marriage that flourished during his time in Nashville, family is a top priority. “Success for me is having a great work/life balance,” Tyler reflects. “Having a happy and healthy family and just becoming 1% better every day.”
Tyler and his family enjoy exploring what DFW has to offer, as well as traveling to places like Nashville, Florida, and Puerto Rico, where his wife’s family lives. When he’s not working, Tyler can often be found hunting, fishing, or spending time with his loved ones.
As Tyler looks to the future, his goals are as ambitious as ever. “Growing my book of business by 100% year over year,” he shares. “I’ve already beaten that goal this year, but I am continually servicing my clients and business relationships at the highest level to further that.”
In a field where the only constant is change, Tyler Coleman has found a way to thrive by focusing on the details, building strong relationships, and always striving for excellence. His journey from a reluctant mover to a branch manager leading one of the largest offices at Black Tie Moving is a testament to what can be achieved with hard work, dedication, and a passion for serving others.
For Tyler, the secret to success is simple: “If you take care of the little things, the big things will take care of themselves.” And in the world of moving, where every little thing matters, that’s advice worth following.












WRITTEN BY KATHERINE H. FONDREN • PHOTOS BY JIN KIM, URSPECIAL
Lisbeth Arias stands out in the real estate industry for one simple reason: she leads with heart.
“I want my clients to feel seen, heard, and valued,” says Lisbeth, co-owner and supervisor of Cedar Creek Lake Real Estate. “Whether I’m helping someone buy their first home or mentoring a brandnew agent, it’s never just about the transaction—it’s about the relationship, the trust, and the impact I can make on their life.”
That intentional, heartfelt approach didn’t come from a textbook or a training manual—it

was forged through decades of grit and deep faith.
Born in El Salvador, Lisbeth was brought to the U.S. as an infant by parents chasing the American Dream. She spent her childhood in Irving, Texas, before the family settled in Grand Prairie. One of her most vivid memories is of her parents buying their first home—a moment that shaped her definition of stability and success. “That house meant everything to us. It represented sacrifice, achievement, and hope,” she reflects.
As the oldest daughter in a Spanish-speaking household, Lisbeth was translating legal documents and doctor’s visits before most kids were allowed to cross the street alone. Alongside her sister, she helped her parents run their family-owned, buy-herepay-here car business for over 20 years. “I didn’t realize it then, but I was learning how to lead—with hustle, compassion, and tenacity. It taught me to solve problems, connect with people, and do business with integrity,” she says.
Real estate came into her life almost by accident—what started as a house flip with her husband in 2018 turned into a full-blown calling. By 2019, Lisbeth was licensed and all in. “I discovered a passion I didn’t know I had,” she explains. “I fell in love with the strategy, the creativity, the way it allows you to build something meaningful for other people.”
Six years later, she’s helped families secure the keys to their first homes, guided overwhelmed clients through hard decisions, and even prevented foreclosures—not through

aggressive sales tactics, but by simply listening.
“There was one client who reached out about listing their home. But after really sitting with them and hearing their heart, I realized they didn’t want to sell—they were just scared and didn’t know their options,” she recalls. “I walked them through solutions like refinancing or a HELOC, and in the end, they were able to keep the home they loved. They cried from relief—and I cried with them. That’s what this job is really about.”
Lisbeth’s journey has never followed a neat or conventional path. She admits the early years of her business were a whirlwind of “wearing all the hats and running on adrenaline.” It wasn’t until a series of personal health challenges forced her to slow
down that she learned the value of building systems and creating balance. “That season taught me to work smarter, delegate where I can, and put my well-being first—because I can’t pour from an empty cup.”
Today, she’s just as passionate about mentoring up-and-coming agents as she is about closing deals. “I tell new agents all the time: This industry isn’t about sales—it’s about service. You build trust, you stay consistent, and you show up with heart,” she says.
Her advice? “Establish systems early on. Stay rooted in your ‘why.’ And remember, we are solutionists. That wisdom came from my first mentor, Sarah Hallum, and it’s never left me.” Despite a thriving business—$52 million in career volume and counting—Lisbeth’s definition of
success is refreshingly unmaterialistic. “Success to me is impact. It’s raising kind, confident children. It’s being a supportive wife. It’s waking up with purpose and building a legacy my family can be proud of,” she shares.
At home, Lisbeth is a proud mom of two boys, ages 17 and 11, and lives on a 54-acre ranch where she and her family tend to cattle, goats, horses and chickens. It’s a far cry from the polished showings and contracts of her day job, but it keeps her grounded. “People see the real estate side of me, but the ranch, the running, the movie nights with my boys—that’s my heartbeat.”
Looking ahead, her 2025 goals are anchored in growth and balance. She’s committed to expanding her brokerage’s reach, strengthening her team culture, and continuing to pour into her agents and community. On a personal level, she’s focused on fitness, quality time with her family, and carving out peaceful moments— preferably on horseback (with fewer falls, she jokes).
Her love for the Dallas-Fort Worth, East Texas and Cedar Creek Lake areas runs deep. “The diversity, the food, the people—it’s like no other place,” she says. “I see this region becoming a national hub for innovation and growth, but what makes it special is the way it still feels like home. That neighborly connection? It’s still here.”
In every part of her life—whether it’s navigating a complicated real estate deal, mentoring a new agent, or riding across her ranch at sunset— Lisbeth Arias shows us what’s possible when you lead with faith, serve with purpose, and stay true to who you are.

“Nothing about my story is traditional,” she says with a smile. “But that’s the beauty of it. I’m proof that you don’t have to sacrifice kindness, authenticity, or community to build something meaningful. You just need heart—and a little grit.”



In a world that often prizes speed and sales over sincerity, Nathan Mutchler is a breath of fresh Texas air. With a heart that beats for his family and a purpose rooted in helping others, Nathan has spent the last 14 years in real estate doing far more than selling houses— he’s been building legacies.
“I’m really not sure what I want people to take away from my story,” Nathan says humbly. “Probably that I love and adore my wife and kids—and that I love helping people of all backgrounds achieve homeownership.” And that simple but powerful mission has guided him through every high and low.
Nathan grew up in Euless, Texas, a diverse community nestled next to DFW Airport. A proud graduate of Trinity High School, he not only ranked in the top 5% of his class but also led his soccer team to a district championship as captain. That passion for teamwork followed him to Texas Wesleyan University in Fort Worth, where he earned both athletic and academic scholarships. He graduated with honors and a business management degree, once again captaining a championship soccer team.
Before real estate, Nathan wore many hats—running a small car lot, coaching soccer, and managing a company that installed lab equipment across Texas and Louisiana. But in 2011, he found his calling in real estate. “From my very first transaction, I was hooked on helping people achieve homeownership,” he says. “Especially those who never thought it would be possible.”

What fuels Nathan’s fire is far from flashy. It’s not about awards—though he’s landed on top producer lists and was recently named one of RP’s Top agents. “I don’t really do this for the awards,” he admits. “I do it because of what it means to people.”


And the people he helps often carry stories that mirror his own. Nathan knows what it means to struggle. He’s faced injuries that derailed his athletic career, nearbankruptcies in business, and slow seasons in real estate. But he’s never stopped. “I just refuse to let [setbacks] stop me, or even slow me down,” he says. “You have to keep moving forward.”
That drive isn’t something Nathan credits to himself alone. He’s quick to honor the ones who’ve lifted him up along the way—especially Ty and Carmen Williams, his Broker and his Broker’s wife. “Ty has believed in me since the moment we met,” Nathan says. “When I’ve doubted myself, he’s been there to pick me right back up. He has the biggest heart in the world. I’d follow Ty to the ends of the earth if he asked me to.”
Then there’s Carmen. “Carmen is a ray of sunshine
when the world is dark. She always has a hug and a smile,” he shares. “But she’s also fiercely loyal—if you mess with her people, watch out. She’ll help you back up when you fall, and she’ll never let you feel like you’re alone.”
This theme of loyalty runs deep in Nathan’s life. It’s what defines his approach to real estate, where he often gives credit to his buyers, puts their needs first, and never prioritizes commission over care. “I don’t think about the money,” he says. “I think about the families I get to help.”
Helping first-time buyers— and often first-generation homeowners—holds a special place in his heart. “It makes me so happy,” Nathan says. “That’s what this is all about for me.”
But beyond business, it’s his own family that grounds him. Nathan and his wife
Kallie, whom he met in 2008, are raising two sons, Cason and Luke, in Burleson. Their home is filled with the joyful chaos of a bloodhound named Mac, a cat named Henry, and a rotating cast of amphibians, reptiles, and fish. “My family is my number one priority,” he says. “I take the boys to school almost every day and never miss their school activities.”
They’re a family that loves to travel, hunt through antique malls in small towns, and attend the Scarborough Renaissance Festival—often in full costume. “Cason is a master of costumes,” Nathan laughs. “He and I dress up as Star Wars characters, and Luke and I love taking the TRE to Dallas and Grapevine.”
Through all of life’s adventures, Nathan’s favorite moments are often the quiet ones—like exploring The Drover in the Fort Worth Stockyards with Kallie or
playing disc golf with the boys at Bailey Lake. “I love Fort Worth,” he says. “It’s modern, but it’s still in touch with its roots. It feels like a small town, and there’s always something meaningful to do.”
While Nathan doesn’t set traditional business goals, he’s deeply intentional. “If all my transactions end with people being happy with the outcome, then my goals have been met,” he says. That kind of success isn’t flashy—it’s real.
Asked what advice he would give to new agents, Nathan doesn’t hesitate. “Never give up. Never say ‘no’ to something because it’s new or confusing. Ask for help. Keep learning. And remember—everyone deserves a chance to own a home, no matter how long it takes or how difficult the journey may be.”
Nathan’s legacy won’t be measured in plaques or dollar signs—it’ll be in the people he’s helped, the families he’s empowered, and the children he’s raised with love, grit, and a sense of purpose. “Success,” he says, “is making a positive impact and being there for your family—in the good and the bad.”
And that’s exactly what he’s done.



WRITTEN BY KATHERINE H. FONDREN
PHOTOS BY KATHERINE GANN, DAYDREAM PHOTOGRAPHY
LOCATION: LISTING AT 319 VERNA TRAIL, FORT WORTH, OFFERED AT $13.5M
If you’ve spent any time in Fort Worth real estate, chances are you’ve heard of Michael Hoover. With 29 years in the industry, a signature cowboy hat, and a heart for helping others succeed, Hoover is more than a seasoned agent—he’s a culturebuilder, mentor, and proud Texan with a deep devotion to the people he serves.
Michael grew up in Crawford, Texas, on a horse ranch where his family bred quarter horses for racing and showing. “I found early success in the show ring with reining horses,” he shares. “It taught me discipline, patience, and the value of perseverance.”
These qualities stayed with him, shaping a work ethic that was inspired by his father—a commercial contractor and developer. “I was exposed to real estate and construction from a young age. I’ve always strived to earn the same level of respect in my career that he did in his.”
After earning a BBA from Angelo State University, Michael spent a few years in retail management before taking a leap into the real estate world. He got his start working for a land developer in 1996. “From there, my passion for real estate grew naturally,” he recalls. That passion has fueled
nearly three decades of impact in the Fort Worth market, but these days, it’s not the closings or commissions that drive him—it’s the people he serves.
“I genuinely enjoy mentoring and supporting agents,” he says. “Helping others grow and being a part of their success is what truly motivates me every day.” As regional vice president at Christie’s International Real Estate @Properties Lonestar, and the leader of Hoover Group Realty, Michael sees his role as much more than operational. “It’s truly a blessing to be in a position of leadership at such a great company. I take pride in being both knowledgeable and accessible—someone my team can count on.”
Michael gives credit to the many mentors he’s had over the years. “I’ve learned that mentorship evolves as you grow,” he says. “Early on, mentors like JD Hoskins and Marcus Smith taught me the fundamentals of sales and the psychology behind it.”
More recently, mentors like Mark Johnson and Jerry Mooty have guided Michael in leading a company and building a strong, intentional culture. “Jerry Mooty, our CEO, allowed me to build a
culture that is true to his company but also true to the Fort Worth culture,” says Michael. “After an initial 3 hour meeting between him and me, Jerry decided to bring Christie’s to Fort Worth and give me the reins to lead it.”
Michael also acknowledges that mentorship doesn’t always come from above—it can also be found in your peers. “One of my closest peers and friends is Tricia Andrews,” Michael explains. “Although we lead different companies, we often reach out to one another to talk through ideas or challenges. It’s a true spirit of collaboration, and I value that kind of mutual support very much.”
That accessibility and devotion to agent success hasn’t gone unnoticed. While he’s received numerous industry accolades— Top Producer awards, Listing Agent of the Year—none have meant more than the “Tender of the Herd” award. “It was given to me by our staff and agents,” Michael says. “Their words truly moved me. That one choked me up—it’s the most meaningful award I’ve ever received.”
Michael’s leadership style is rooted in simplicity and consistency. His motto for agents

is one he lives by: Wake Up. Dress Up. Show Up. “There are so many things out there to distract us from our business. You can get taken off track quickly without a firm hand on the wheel.” He also explains that leadership is easy when you have a team of leaders working with you. “I lean on Sara O’Canna, Director of Agents, and Leslie Potenzo, Agent Services, who are caring and full of positive energy. Who you work with matters in this business!”
And while he’s a firm believer in hustle, Michael knows that success is more than numbers. “Success is about work/life balance. If you can be a success without sacrificing the little moments in life, I would say that is ultimate success.” It’s a value he’s practiced throughout his own career. “Real estate has allowed me to make my own schedule. I focused on being there for my kids—taking them to school and picking them up. I’m proud of that.”
At the core of Michael’s success is his deep commitment to culture— something he believes sets Christie’s apart. “We’re focused on continued growth—with the right people,” he explains.
“Growth is important, but only when it aligns with our culture and the character of our company. We’re building a team that not only excels professionally but also contributes to a supportive, values-driven environment.”
He calls it a “culture of camaraderie,” and anyone who knows Michael knows it’s not just a catchphrase. His leadership is rooted in real relationships, intentional mentorship, and high standards. “Communication is key to continued success,” he says. “I think what sets me apart is personal care and communication.”
When asked what he wants to be remembered for, Michael doesn’t hesitate. “Leadership and helping others grow through culture and commitment.” And while he’s not as focused on personal production these days, his career volume is in the hundreds of millions. His impact, however, can’t be measured in numbers alone. It’s in the agents he’s guided, the careers he’s helped shape, and the company culture he continues to nurture.
Outside of real estate, Michael finds joy in the simple pleasures
of life. He’s been married to his wife Julie for 32 years and is a proud father to Jarod, a Realtor in Florida, and Jorja, a senior at Baylor University. “Family is everything to me,” he says.
When he’s not mentoring agents or empowering a high performance culture, you’ll find him on the water with his family, tinkering with one of his old British sports cars, or obsessing over his lawn. “I know it’s crazy,” he laughs, “but I am a stickler about having the best yard in the neighborhood.” And if you catch him singing along to the Bee Gees? Don’t be surprised. “Call me crazy, but the Bee Gees are timeless.”
It’s that blend of old-school charm, heartfelt leadership, and integrity that defines Michael Hoover. He’s not just helping agents sell homes— he’s helping them build legacies. And in Fort Worth, where cowboy culture meets big city ambition, there’s no better trail boss for the job.
One of the most important lessons I’ve learned is the value of surrounding yourself with people who believe in you—and in whom you can place your trust. Through every stage, one constant has remained: integrity is the backbone of a lasting reputation.”
















Congrats on earning your Real Producers Top Agent Badge!
Congrats on earning your Fort Worth Real Producers Top Agent Badge!
Because of your 2024 MLS production you earned your spot as a 2025 Real Producers Top Agent and can represent your badge proudly! Depending on your production will determine if you received the Top 500 or Top 1000. Regardless, that is the top 6% in Fort Worth!
Missing your badge? Email team@dfwrealproducers.com.
Using your badge? We’d love to see how! Show us how you are using your badge, and you may just find a picture of what you shared in the magazine! Social media, email signatures, web listings, marketing material... nothing’s off limits!
Our preferred partners have been carefully selected to be a part of this community and have their own badge as well! They have been recommended by your peers and are some of Fort Worth’s most elite businesses. Look for this badge to know that you are working with one of the best, recommended by the best!

Greg Esquilino and his wife wanted to bring DFW a roofing company that would push communication and high values over all else. He noticed that lack in the industry since he first started in roofing

Brendan Thomas, a lifelong friend of Greg's, shared this vision and ultimately joined Greg. He and Greg are expanding their services across DFW and East Texas, creating long lasting relationships.





